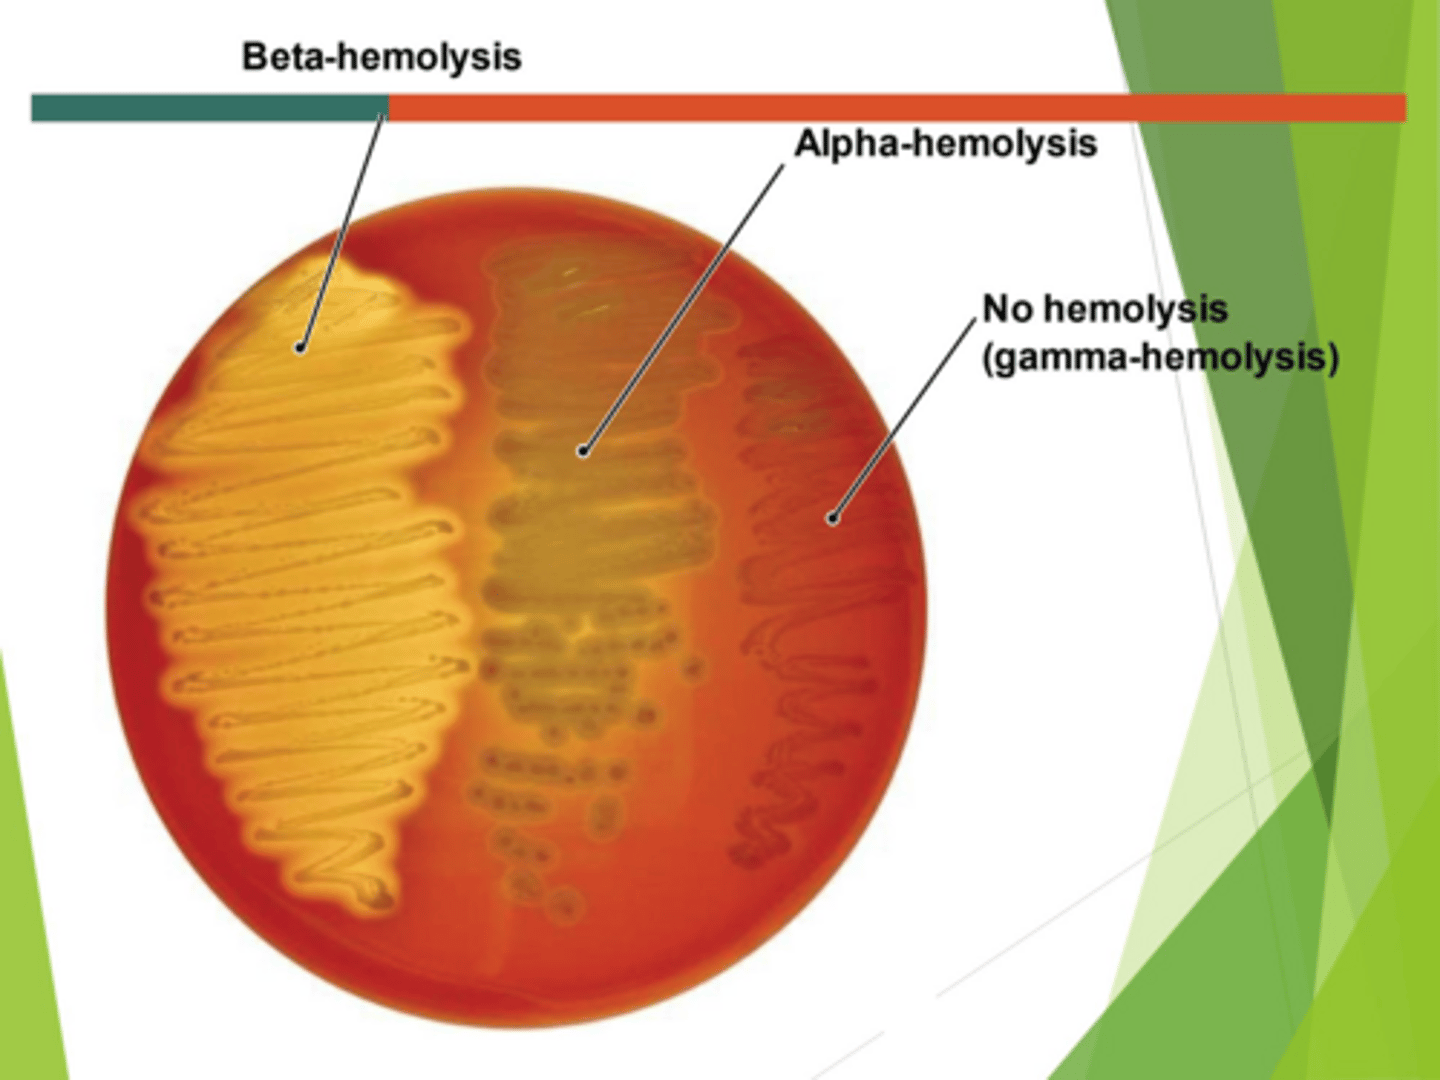
<p>Beta</p>

1/52
Looks like no tags are added yet.
Name | Mastery | Learn | Test | Matching | Spaced | Call with Kai |
|---|
No analytics yet
Send a link to your students to track their progress
What genes are located on the pGLO plasmid?
AraC gene, GFP gene, and bla gene.

What does the AraC gene do?
It produces a repressor protein for the GFP gene.
What happens to the GFP gene in the presence of Arabinose?
Arabinose removes the repressor, allowing transcription and translation of the GFP gene.
What is the function of the GFP gene?
It makes the bacteria glow green.

What does the bla gene provide resistance against?
Ampicillin.
What enzyme does the bla gene produce?
Beta-lactamase.
What does 'competent' mean in a bacterial context?
Able to take up a plasmid.
How is E. coli made competent?
By mixing with calcium chloride and heat shocking.
What is the regulation mechanism of GFP gene expression?
It is regulated by the AraC repressor and Arabinose.
What is the macroscopic appearance of mold?
Surface and reverse pigment, height of aerial hyphae.
What are the terms used to describe the height of aerial hyphae?
Cottony, Velvety, Wooly, Powdery.
What is the catalase test used for?
To determine the ability of bacteria to produce the enzyme catalase.
What is the catalase test result for Staphylococcus?
Positive.
What is the catalase test result for Streptococcus?
Negative.
What does the coagulase test determine?
The ability of bacteria to produce bound coagulase.
What reagent is used in the coagulase test?
Rabbit plasma.
What indicates a positive coagulase test?
Clotting with a clear background.
What is Mannitol Salt agar used for?
To grow and differentiate Staphylococcus species.
How does Staphylococcus aureus differ on Mannitol Salt agar?
It ferments mannitol.
What is the salt tolerance of Staphylococcus species on Mannitol Salt agar?
They can grow in 7.5% salt.
What is the glucose fermentation result for Staphylococcus aureus?
Positive.
What is the pigment production of Micrococcus roseus?
Rose-Coral.
What is the nitrate reduction result for Staphylococcus epidermidis?
Positive.
What is the significance of Mannitol Salt agar being selective and differential?
It allows growth of salt-tolerant Staphylococcus and differentiates based on mannitol fermentation.
What is the catalase result for Staphylococcus aureus?
Positive
What is the glucose fermentation result for Micrococcus luteus?
Negative
What is the coagulase result for Staphylococcus epidermidis?
Negative
What is the salt tolerance result for Micrococcus roseus on Mannitol Salt Agar?
Negative
What color pigment does Micrococcus luteus produce?
Yellow
What is the nitrate reduction result for Micrococcus roseus?
Positive
What type of hemolysis does Streptococcus pyogenes exhibit?
Beta
What is the optochin sensitivity result for Streptococcus pneumoniae?
Sensitive (Positive)
What is the bile esculin result for Enterococcus faecalis?
Positive
What is the hemolysis type for Streptococcus sanguinis?
Alpha
What is the catalase result for Enterococcus faecalis?
Negative
What color do lactose fermenting colonies appear on MacConkey Agar?
Hot pink
What is the result of the nitrate reduction test for Staphylococcus aureus?
Positive
What is the hemolysis type for Group C Streptococcus?
Beta
What is the catalase result for Streptococcus pneumoniae?
Negative
What is the significance of using the streak-stab method for blood agar inoculations?
It enhances the appearance of hemolysis.
What atmosphere is used to grow Streptococcus?
Candle jar - microaerophiles and capnophiles
What is the result of the bile esculin test for Streptococcus pyogenes?
Negative
What is the hemolysis type for Streptococcus pneumoniae?
Alpha
What is the result of the latex agglutination test for Group A antibodies?
Positive reaction
What are the characteristics of Enterobacteriaceae?
Gram-negative bacilli, ferment glucose, do not produce oxidase, reduce nitrate to nitrite.
What is the result of the oxidase test for Non-Enterobacteriaceae?
Many (but not all) are oxidase positive.
What is the significance of MacConkey Agar in bacterial identification?
It is selective for Gram-negative organisms and differential for lactose fermentation.
What is the result of the lactose fermentation test for clear colonies on MacConkey Agar?
Negative for lactose fermentation.
What is the result of the nitrate reduction test for Micrococcus luteus?
Negative
What is the result of the glucose fermentation test for Staphylococcus epidermidis?
Positive
What is the result of the coagulase test for Staphylococcus aureus?
Positive
What is the pigment production for Micrococcus roseus?
Rose-Coral
What is the result of the optochin sensitivity test for Streptococcus sanguinis?
Resistant (Negative)